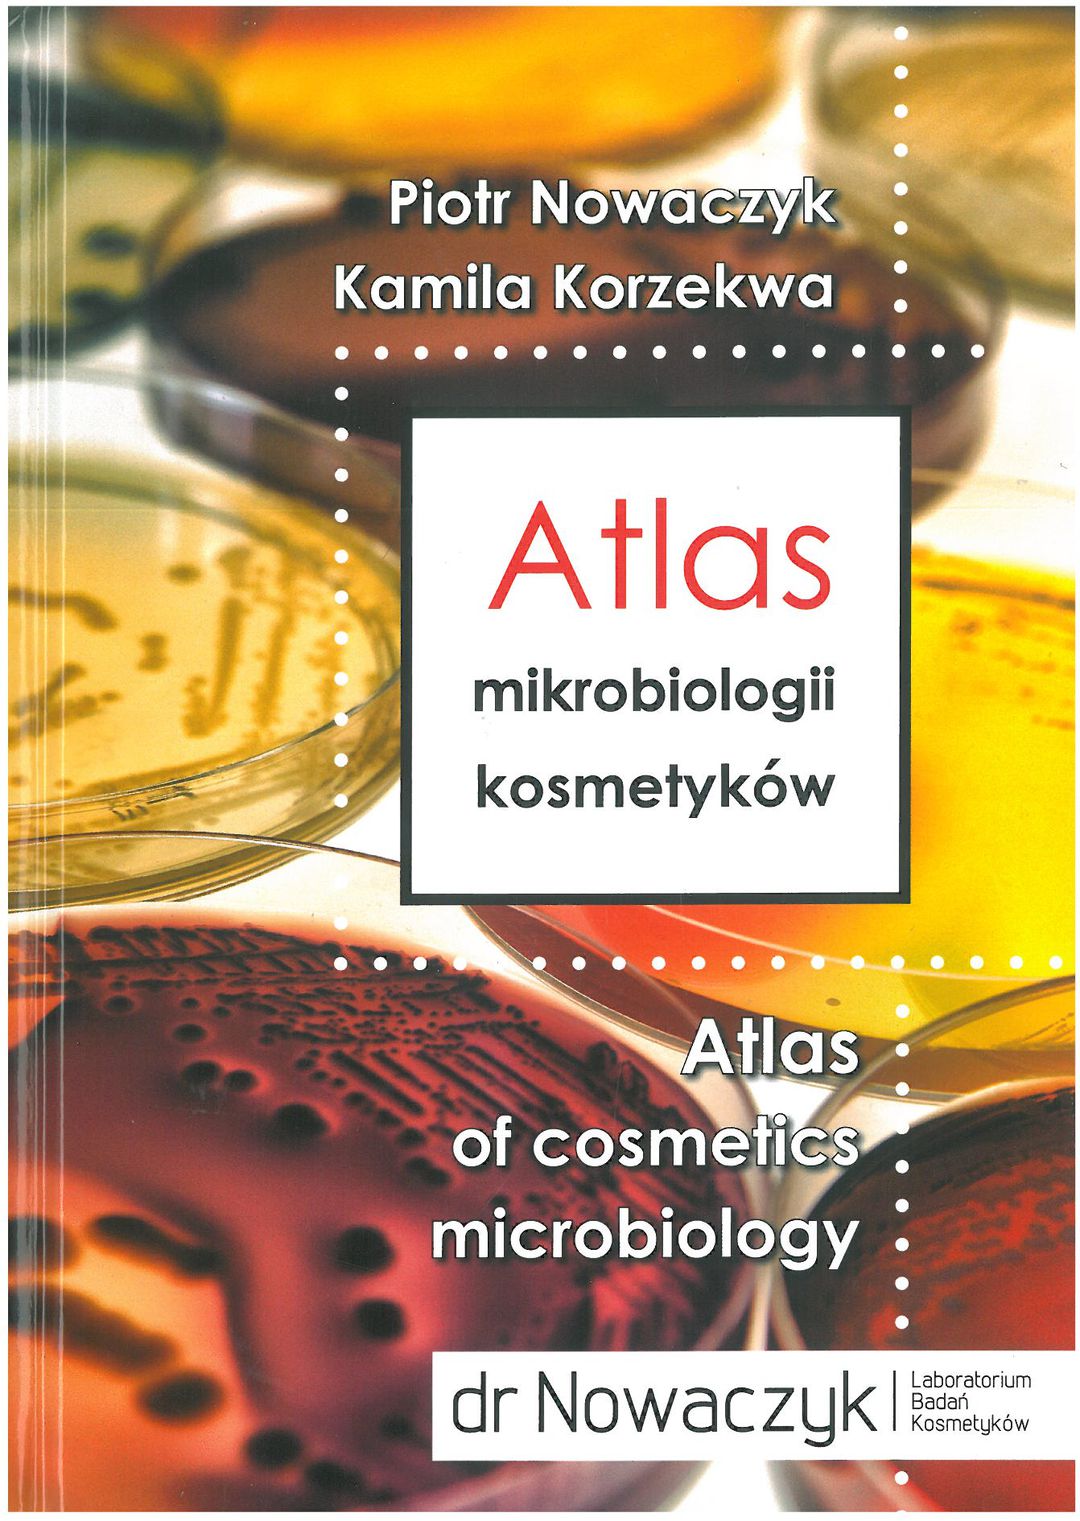

Atlas mikrobiologii kosmetyków
| Inne tytuły: | Atlas of cosmetics microbiology |
|---|---|
| Autorzy: | Piotr Nowaczyk Kamila Korzekwa |
| Wydawca: | Wydawnictwo Poligraf (2017) |
| ISBN: | 978-83-7856-666-3 |
| Autotagi: | druk książki publikacje fachowe |
| Źródło opisu: | Biblioteka Miejska w Imielinie - Katalog księgozbioru |
|
|
|
Wypożycz w bibliotece
Kup
Recenzje